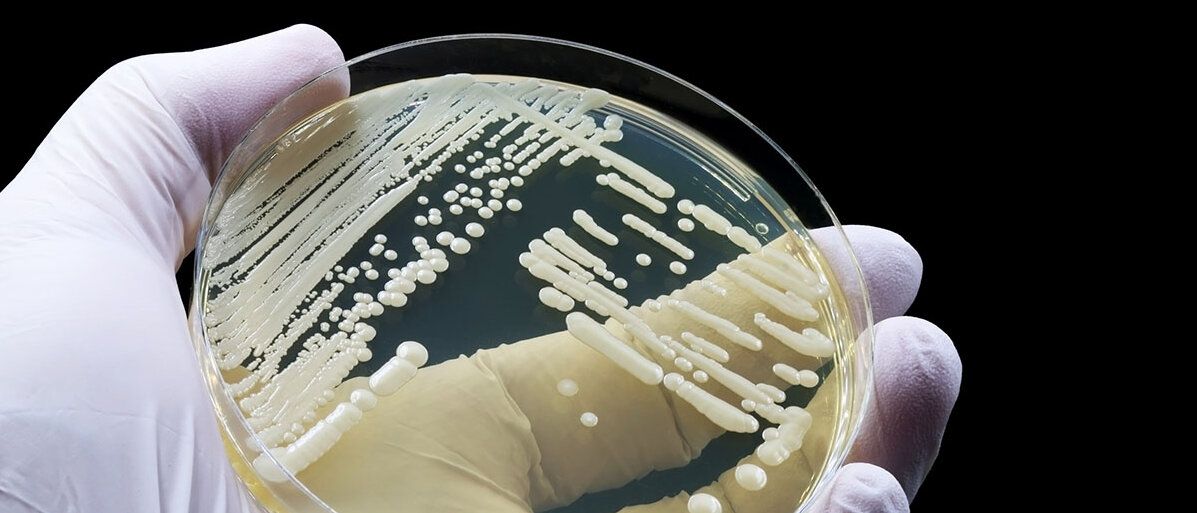

Mehrere Angriffspunkte
NEUER WIRKSTOFF SCHALTET MULTIRESISTENTE PILZE AUS
Seite 1/1 3 Minuten
Forschende haben einen neuen Wirkstoff gegen multiresistente Pilze entdeckt, der die Zellmembran auf eine bisher unbekannte Weise zerstört. Dafür hat das Team mit einer völlig neuen Methode gesucht und die Gene Hunderttausender Bakterien durchleuchtet.
Bisherige Wirkstoffe gegen Pilzinfektionen wie Nystatin und Amphotericin B stammen zwar ebenfalls aus Bakterien, aber die neue Substanz hat ihnen einiges voraus.
Neuer Wirkstoff greift multiresistente Pilze gleich mehrfach an
Der neue Wirkstoff mit dem Namen Mandimycin nimmt es mit multiresistenten Pilzen gleich mehrfach auf. Bisher bekannte Wirkstoffe, die bei Pilzinfektionen zum Einsatz kommen, binden an ein Membranprotein namens Ergosterol. Mandimycin, ein sogenanntes Polyen-Makrolid, hat gleich mehrere unterschiedliche Membranbestandteile zum Ziel. Die Pilzzelle wird regelrecht löchrig und stirbt ab. Das Team um Qisen Deng von der Chinesischen Pharmazeutischen Universität in Nanjing hat den neuen Wirkstoff bereits erfolgreich an Mäusen getestet, die mit einem multiresistenten Pilz infiziert waren.
Mandimycin erwies sich sogar als wirkungsvoller als das bisher eingesetzte Medikament gegen solche Pilzinfektionen, Amphotericin B.
Auf den neuen Wirkstoff, der auch den gefürchteten multiresistenten Pilzen begegnen kann, kam das Team mit einer neuen Screening-Methode. Der Kampf zwischen Bakterien und Pilzen ist Milliarden Jahre alt; viele Bakterien bilden Wirkstoffe, die man teilweise heute gegen Pilzinfektionen einsetzt. Sie stammen meist aus Bodenproben. Diese Methode des aktivitätsbasierten Screenings liefert zwar neue Wirkstoffe, aber oft solche mit bereits bekannten Wirkmechanismen. Gegen multiresistente Pilze wie Candida auris nützen diese wenig.
Deng und seine Kolleg*innen durchsuchten die Genome von über 300000 Bakterienarten nach Genclustern, die den Code für potenzielle neue Wirkstoffe gegen Pilzinfektionen enthalten könnten. Diese sortierten die Forschenden nach ihrer evolutionären Entstehung und konnten so die modernsten Varianten heraussuchen. So stießen sie auf den neuen Wirkstoff, der möglicherweise eine neue Waffe im Kampf gegen multiresistente Erreger sein könnte.
Mehr über multiresistente Pilze:
Medikamente sollen gegen Pilzinfektion wirken, nicht gegen eigene Zellen
Was den neuen Wirkstoff gegen multiresistente Pilze so effektiv macht, ist, dass gleich mehrere unterschiedliche Membranbestandteile der Pilzzelle angegriffen werden. Das macht es für die Erreger schwieriger, Resistenzen zu entwickeln, die meist auf einem bestimmten Protein basieren. Ein Problem: Die Targets des neuen Wirkstoffes finden sich nicht nur in den Zellen multiresistenter Pilze, sondern auch in Säugetieren.
Der neue Wirkstoff hält zwar multiresistente Pilze gut in Schach, wirkt aber nicht nur dort. Die Membranbestandteile, gegen die Mandimycin gerichtet ist, existieren nämlich auch in Säugetierzellen. Während niedrigere Dosen des Medikamentes effektiv gegen Pilzinfektionen sind, wirken höhere Konzentrationen nierentoxisch auf Mäuse und sind giftig für menschliche Nierenzellen. Es scheint aber so zu sein, dass der neue Wirkstoff in geringen Mengen bereits zuverlässig gegen multiresistente Pilze wirkt.
Bevor aus Mandimycin ein neues Medikament gegen Pilzinfektionen entwickelt werden kann, wird es aber noch dauern. Denn bisher wurde der neue Wirkstoff zwar in Mäusen gegen multiresistente Pilze getestet, aber noch nicht bei Menschen erprobt. Daher steht noch viel Forschung an. Im Unterschied zu Amphotericin B, das gespritzt werden muss, kann aus Mandimycin wahrscheinlich ein wasserlösliches, oral verfügbares Medikament gegen Pilzinfektionen gewonnen werden. Es bleibt zu hoffen, dass der neue Wirkstoff bald auch multiresistenten Pilzen ihren Schrecken nehmen kann.
Quellen:
https://www.wissenschaft.de/gesundheit-medizin/neuer-wirkstoff-gegen-multiresistente-pilze/
https://www.nature.com/articles/s41586-025-08678-9
https://kurier.at/wissen/gesundheit/pilzinfektionen-multiresistente-pilze-mandimycin/403024095